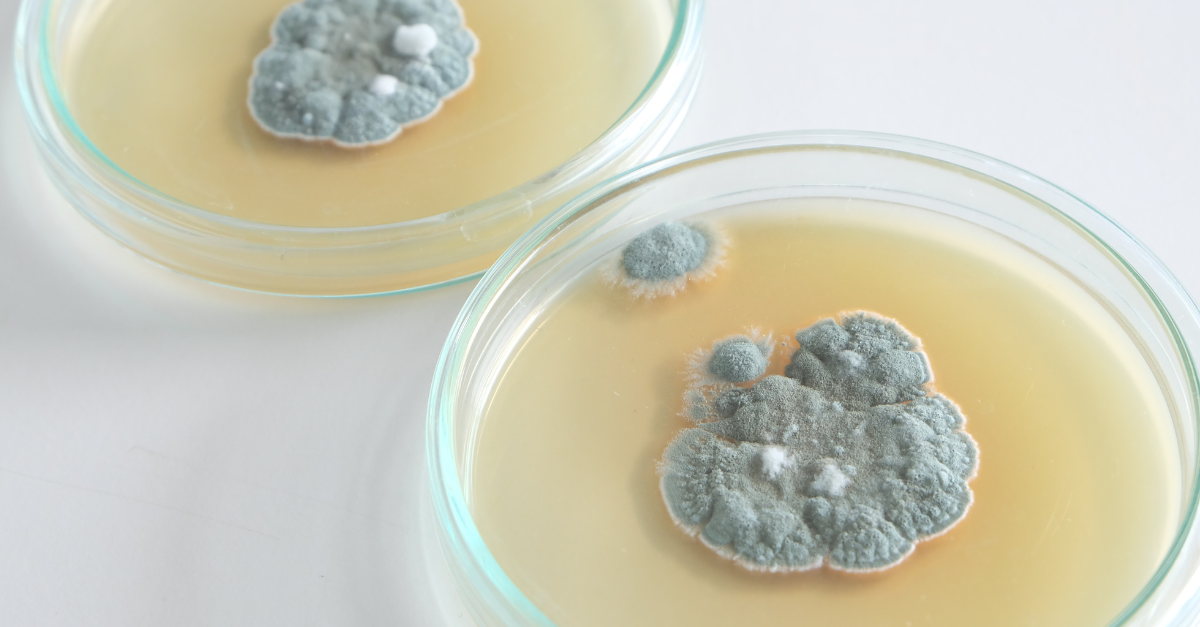

Dnešný svet je plný úžasných vynálezov, ktoré nám uľahčujú každodenný život. Veľa z nich však vzniklo úplne náhodou a sú o to úžasnejšie. Je na tom niečo špeciálne, keď sa niečo podarí a pritom vynálezca si myslí, že všetko je zmarené a pokusy sa nevydarili. A pritom vznikne niečo ešte oveľa lepšie ako, o čo sa pokúšali.
Rok 1827 – Zápalky

Keď milujete experimenty s chemikáliami, nie vždy to musí dopadnúť dobre. Britskému chemikovi Johnovi Walkerovi sa však nechtiac podarilo vytvoriť niečo, čo používame dodnes a vtedajším ľuďom uľahčil život úplne úžasným spôsobom. Prišiel na to tak, že vytvoril lepkavú zmes sulfidu antimonitého a chlorečnanu draselného, ktoré mal na konci paličky. Keď sa pokúsil zmes zoškriabať, tak mu to vzbĺklo. Nazval ich „Trecie svetlá Johna Walkera“.
Rok 1878 – Sacharín

Ruský chemik Constantine Faglberg objavil látku, ktorá je 300 až 400 krát sladšia ako cukor. Keď skúšal analyzovať chemické vlastnosti uhoľného dechtu, zabudol si umyť ruky a potom všetko, čo si priložil k ústam, bolo sladké. Rožok, ktorý mal na obed, obrúsok, voda, ktorej sa napil…takto objavil sacharín.
Rok 1886 – Coca Cola

Možno ste nevedeli, že coca cola mala byť pôvodne na zranenie utrpené v americkej občianskej vojne. Biochemik John Pemberton sa stal kvôli smerteľnej rane závislým na morfiu a chcel sa toho zbaviť. Svojimi experimentami vytvoril sirup z listov koky a kolových listov. Jeho asistent ho potom omylom zmiešal so sýtenou vodou a prvý predchodca coly bol na svete. Škoda, že sa pán Pemberton nedožil svojho globálneho vplyvu na priemysel nealkoholických nápojov.
Rok 1895 – Röntgen

Moderný röntgen bol pomenovaný po svojom objaviteľovi Wilhelmovi Röntgenovi a vznikol, keď experimentoval katódovými trubicami a vtedy si všimol fosforescenciu na neďalekej obrazovke. Nechcel aby sa mu experiment pokazil, tak sa snažil blokovať žiarenie z trubíc. Nakoniec neuveriteľne zistil, že kosti jeho ruky sú otlačené na obrázku. Takto omylom bol vynájdený moderný röntgen.
Rok 1903 – Nerozbitné sklo

Francúzsky vedec Benedictus vynašiel nerozbitné sklo tak, že spadol na skúmavku, ktorá bola pokrytá vrstvou zlúčeniny celulózy, s ktorou celý deň experimentoval. Vrstva bola v skúmavke taktiež úplne náhodou, lebo mu tam počas experimentu kvapla. Po svojom páde na danú skúmavku prišiel na to, že sa nerozbila a tak vynašiel nerozbitné sklo.
Rok 1928 – Penicilín
Škótsky biológ Alexander Fleming odišiel na dovolenku a na svojom pracovnom stole nechal otvorenú Petriho misku s jedlom. Keď sa vrátil všimol si, že ta vyrástla zeleno – modrá pleseň, ktorá „zjedla“ jedlo z Petriho misky. Keby tam nebol misku zabudol, ktovie či by sme mali penicilín k dispozícii.
Rok 1941 – Suchý zips

Aj vy ste sa v detstve hrali s lepkavými „cigánskymi gombíkmi“ bodliaka a lepili ste si ich na šaty? To sa stalo aj švajčiarskemu inžinierovi Georgesovi de Mestralovi, ktorého to však po prechádzke naštvalo. Potom však začal premýšľať, ako je možné, že sa na všetko prichytia a začal ich skúmať. Prišiel na to, že fungujú na princípe malinkých háčikov a použil to ako predlohu na suchý zips.
Rok 1945 – Mikrovlnka

Inžinier Percy Spencer pracoval na novej na magnetrónovej trubici, ktorá by mohla vysielať vysoké vlny energie. Keď okolo trubice prechádzal, všimol si, že čokoláda v jeho vrecku sa rozpustila. Zaujalo ho to a preto urobil pokus aj s kukuricou. Tá začala pri trubici pukať do popcornu. Takto bola vynájdená prvá mikrovlnná rúra. Bola vysoká cca 1,5 m a trvalo nejakú dobu kým dostala svoju kompaktnú podobu, ktorú poznáme dnes.
Rok 1956 – Kardiostimulátor

Manželia Greatbatchovci, milovali experimentovanie s rôznymi vecami. Eleanor Greatbatchova akurát pracovala na novom vynáleze, ktorý by nahrával tlkot ľudského srdca a jeho nepravidelné údery. Jej manžel Wilson však omylom namontoval zlý diel a tak prístroj nenahrával tlkot srdca, ale dokázal vytvoriť pulzový výboj sám. A prvý kardiostimulátor bol na svete.
Rok 1996 – Viagra

Začiatkom 90- tych rokov sa testoval nový liek na kardiovaskulárne ochorenia. Liek mal rozširovať cievy v srdci a tak značne prispieť k liečbe ochorení srdca. Počas klinických skúšok, si službukonajúca sestra všimla niečo zvláštne. Prišla na to, že liek rozširuje cievy, ale v mužskom penise a muži, ktorí sa podujali na testovanie lieku, zažívali erekciu. Vďaka tomuto objavu sa izolovala účinná látka a vznikla viagra. Tá odvtedy dovoľuje žiť plnohodnotný život mužom po celom svete.

















